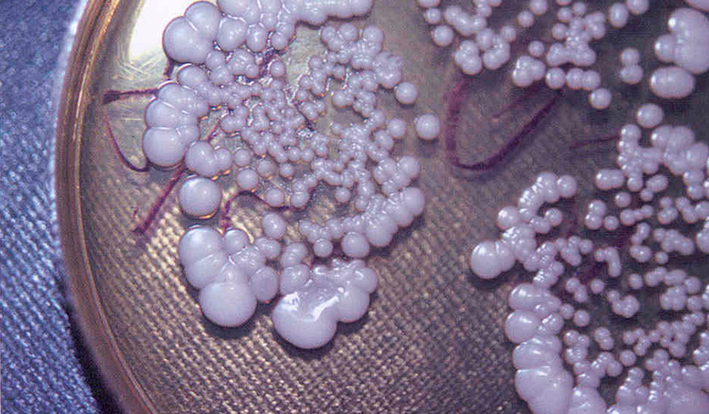
kandidoz

Молочница у женщин
Урогенитальный кандидоз — воспаление слизистой мочеполового тракта, вызванного грибами рода Candida - имеет множество названий: молочница, эндомикоз, кандидамикоз, бластомикоз, левуроз, соормикоз - и это далеко не всё.
Почему молочница?
Так её называли ещё при Гиппократе, потому что находили её у грудничков, видимо, считали, что попадает она в рот малыша исключительно с молоком.
При молочнице грибами поражаются преимущественно наружные оболочки. Но сегодня кандидоз стал более распространённым, к тому же он проникает в организм глубже, во внутренние органы и ткани, и даже вызывая кандидозный сепсис.
Об особенности грибов сосуществовать с человеком всю его жизнь, когда мирно, а когда и агрессивно, знали ещё с XVIII века. Сегодня нередко можно услышать, что будущее инфекций человека определят именно грибы.
Грибы есть везде: в горячем песке пляжа, в прохладной воде бассейна, на скамейке парка, на поручнях эскалатора, на свежевыстиранном белье. Они нас окружают и попадают внутрь. Candida — условно-патогенный организм, то есть существует в организме и за счёт человека, но время от времени вдруг начинает атаковать хозяина, вызывая болезненные симптомы, а потом утихает и живёт незаметно до следующей атаки.
Грибок рода Candida всегда в организме найдётся, и первым делом начнётся развитие его не во рту, где слюна смывает и «вытравливает» ферментами всё лишнее, а на почти беззащитной слизистой половых органов, где не бывает чисто, а собственные полезные лактобактерии — слабые защитники.
Условия активизации грибов
Бытует мнение, что кандидоз как любое грибковое поражение — вестник неблагополучия в организме. Грибы Candida сопутствуют хроническим заболеваниям, пользуются ослаблением защитных сил организма в результате острого заболевания, развиваются на фоне подавления иммунитета лекарственными препаратами. Все эти внутренние процессы создают предпосылки для перехода грибка из сапрофитного, и безвредного для хозяина существования, в сугубо патогенное.
Снижение иммунитета, врождённое или связанное с лечением, к примеру, злокачественных опухолей с помощью цитостатиков, приём глюкокортикоидных гормонов при тяжёлой астме или лекарственное подавление отторжения донорского органа, благоприятны для Candida. При высокодозной химиотерапии некоторых форм злокачественных заболеваний крови и лимфатических тканей параллельно проводится не менее агрессивное лечение противогрибковыми препаратами. ВИЧ-инфицирование становится причиной молочницы так часто, что активизацию грибов косвенно считают признаком увеличения концентрации вируса в крови.
Приём антибиотиков вызывает нарушение баланса микрофлоры, правда, и антибиотики принимают из-за превалирования патогенной бактериальной флоры, так вот антибиотики убивают и плохих и хороших, поэтому на освободившемся от бактерий месте легко заводятся Candida.
Заболевание эндокринных желёз приводит к дисбалансу обмена углеводов. Особенно сахарный диабет, а грибы обожают сладкое — глюкозу. Кроме того, гормональные нарушения меняют обменные процессы в тканях, нарушают сосудистую сеть, ослабляют защитные свойства, что сразу же становится причиной активизации грибов рода Candida.
Хронические заболевания приводят к нарушениям трофики — питания органов и тканей, что мешает адекватной иммунологической защите, способствует активизации любых грибов, и в первую очередь Candida. Грибы чудесно сосуществуют с заболеваниями и инфекциями кожи, туберкулёзом, коллагенозами, хроническими заболеваниями бронхов и лёгких.
Трофические нарушения в тканях и просто старение организма, сопровождающееся дистрофическими изменениями, благоприятны для развития и хронизации кандидоза. Так бывает со слизистой языка у стариков, когда выработка слюны значительно снижена. При тяжёлом варикозе нижних конечностей образуются труднозаживающие язвы, где грибы рода Candida — в первых рядах вредителей.
Молочница и сладкое
Грибы рода Candida любят сладкое — ткани, где много гликогена — формы хранения глюкозы. Слизистая влагалища именно такое «сладкое» грибное место. На кандидозные поражения половых органов приходится более трети всех инфекций, и хотя бы раз в жизни кандидозным вульвовагинитом переболело три четверти женщин, но только у каждой пятнадцатой молочница принимает рецидивирующее течение. После менопаузы грибок почти не тревожит: содержание гликогена падает вместе с уровнем половых гормонов.
Но молочницу не относят к передаваемым половым путём, хоть у партнёра тоже могут развиться клинические проявления кандидозного баланопостита, но причина в другом. Мама может инфицировать новорожденного дрожжевым грибком, но клинические проявления при этом очень редки, потому что необходимы условия их развития. И хоть грибов везде видимо-невидимо, они буквально под ногами, для активизации нужны внутренние подходящие условия.
Какой бывает молочница?
Молочница, или по-научному, кандидоз бывает острым и хроническим или, как называют его в специальной медицинской литературе: неосложнённый и осложнённый. Вторая классификация более «жизненна», потому что хроническим заболевание считается при нескольких повторениях острого процесса в определённый промежуток времени. Кандидоз может быть острым несколько раз, без тенденции перехода в хроническую форму.
Неосложнённый кандидоз возникает время от времени, ежегодно не чаще четырёх раз, при отсутствии выше перечисленных состояний и заболеваний, то есть у здорового человека.
Соответственно, осложнённый это рецидивирующий более четырёх раз за год у пациентов, имеющих что-либо из перечисленного в предшествующей главе.
Деление это весьма условно, потому как рецидивы более четырёх ежегодно могут быть и у здоровых людей.
Бесконтрольное и немотивированное клиническими проявлениями применение противогрибковых препаратов привело к росту устойчивых к лекарствам форм Candida. Доверьте лечение профессионалам, запишитесь на консультацию.
Симптомы молочницы
У мужчин кандидозное поражение чаще проявляется баланопоститом, у женщин — вульвовагинитом.
Беспокоят зуд и жжение в области влагалища и мочеиспускательного канала, при мочеиспускании может возникать обжигающая боль. Отмечаются белые или желтоватые обильные выделения с крупинками похожими на творог. Половой контакт болезненный, слизистая оболочка болезненно чувствительна и отёчна, как будто слегка обожжённая.
У мужчин возникают аналогичные жалобы, но отекает и раздражается нежная кожа полового члена, на ней появляется мелкая красная сыпь, покрытая творожистым налётом, возможно образование болезненных трещинок в коже аногенитальной зоны. Возможна и восходящая инфекция с развитием цистита, но у женщин цистит бывает чаще, потому что мочеиспускательный канал короткий и широкий.

Обострение кандидоза у половых партнёров совершенно не совпадает по времени и частоте, потому как каждый имеет на то свои внутренние и часто совершенно независимые причины.
Диагностика и лечение молочницы
Внешние проявления кандидоза очень характерные, поэтому выявление грибов Candida проводится не каждое обострение. Грибы хорошо обнаруживаются при микроскопии секрета половых путей, их успешно выращивают на питательной среде, параллельно выявляя чувствительность к противогрибковым препаратам. Иногда, по причине отсутствия эффекта от лечения, прибегают к идентификации с помощью молекулярно-биологических методов — по кусочку ДНК вида грибка из родового семейства Candida.
Каждая пятнадцатая женщина имеет бессимптомное носительство грибка рода Candida, поэтому лечить начинают только при наличии клинических симптомов, то есть когда болит и мешает нормально жить, а ни когда в анализе случайно обнаружили грибок Candida.
Из-за развития устойчивых к воздействию лекарств грибов, рекомендуется применение местных средств, а системные — таблетки - назначать при невозможности местного лечения. Необходимо учитывать, что некоторые влагалищные свечи способны «слегка разъедать» латексные презервативы. И ещё никто не доказал пользу параллельного применения спринцеваний или свечей с лактобактериями.
Длительность местного лечения зависит от препарата и его дозы, при выраженных симптомах молочницы проводится курс до двух недель и возможно повышение дозы. Но назначать и контролировать лечение должен гинеколог, в противном случае можно не вылечиться.